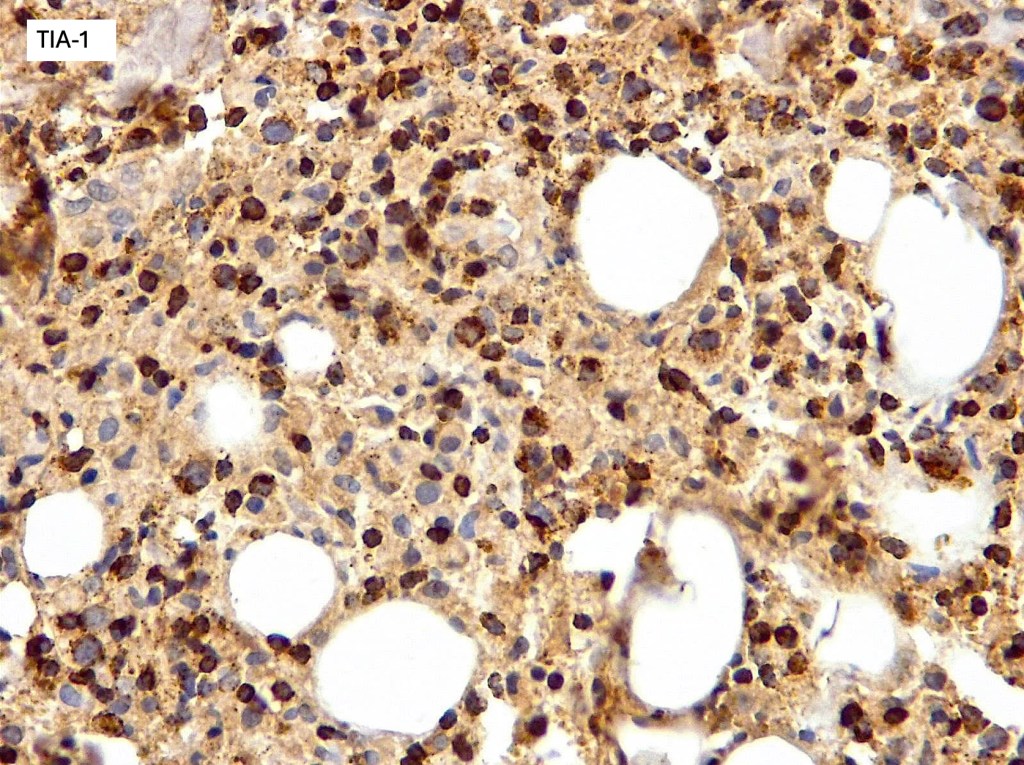

Clinical features
•Aggressive with high mortality
•Extranodal NK/T cell lymphoma, nasal type & aggressive NK-cell leukemia
•Most commonly affects the nasal cavity & upper aerodigestive tract
•Predominantly seen in Chinese, Korean & Japanese populations; rare in Europeans
•Cutaneous involvement may co-exist with nasal lesions or represent the primary site
•Skin lesions include often ulcerated nodules & plaques, vasculitic lesions, panniculitis & cellulitis-like lesions
•Predilection for trunk & limbs
•B symptoms
•Hemaophagocytosis syndrome
Histological features
•Associated with EBV
•Immunosuppression
•Mutation of genes in JAK/STAT pathway
•Variable ulceration & Pseudoepitheliomatous hyperplasia
•Exceptional epidermal involvement
•Dense nodular or diffuse infiltrate of small to large atypical lymphocytes
•Frequent mitoses
•Angiotropism, angiodestruction, thrombi & coagulative necrosis
•Background inflammatory cells
•NK variants- CD2, CD56, CD43, CD45RO & CD3e
•TIA-1, granzyme B & perforin +ve
•CD2, CD4, CD5, CD7 & CD8 –ve
•Germline TCR
•T-cell lineage may be seen in up to 40% of cases with variable expression of T-cell markers, cytotoxic markers and monoclonal TCR

Differential diagnosis
Lymhomatoid granulomatosis is also associated with EBV and an angiocentric/angiodestructive infiltrate but is a B-cell lymphoma with associated reactive T-cells. Other lymphomas which may demonstate angioinvasion & angiodestruction including γ/δ T-cell & subcutaneous panniculitis-like T-cell lymoma may be excluded with IHC & insitu hybridization for EBV.
Leave a comment